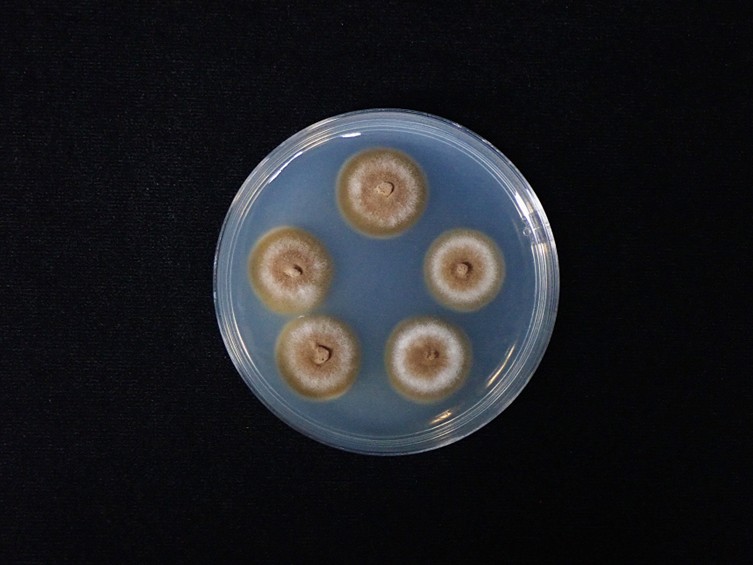

Holotype:
PHILIPPINES, Mindanao Island, Northern Mindanao region, Lanao del Norte Province, Iligan City, Mount Agad-Agad, vegetation on the banks of a mountain stream, 28 Jan. 2022, D.A. Acal, holotype LOD PF4565.
Habitat:
Twig of a tree
Host:
On robber fly (Asilidae, Clephydroneura sp.)
Description:
 Stromata stipitate, two to three stromata arising from the thorax region of host, beneath the wings, capitate, unbranched. Stipes cylindrical, smooth, brownish-orange, 5–8 mm long, 1–1.5 mm wide with a fertile apex. Sexual morph: Fertile head hemispherical to globoid, upper surface slightly convex, moderate orange yellow, located at the tip of stipes, 2–2.5 mm thick, 3–4 mm diam.
Stromata stipitate, two to three stromata arising from the thorax region of host, beneath the wings, capitate, unbranched. Stipes cylindrical, smooth, brownish-orange, 5–8 mm long, 1–1.5 mm wide with a fertile apex. Sexual morph: Fertile head hemispherical to globoid, upper surface slightly convex, moderate orange yellow, located at the tip of stipes, 2–2.5 mm thick, 3–4 mm diam.  Perithecia immersed, ovoid to obclavate, 720–1100 × 240–400 μm.
Perithecia immersed, ovoid to obclavate, 720–1100 × 240–400 μm.  Asci cylindrical, up to 300 μm long, 4–6 μm wide, with cap 4–6 μm thick.
Asci cylindrical, up to 300 μm long, 4–6 μm wide, with cap 4–6 μm thick.  Ascospores filiform, multi-septate, breaking into 64 part-spores, cylindrical to fusoid, 10–12 × 1.5–2.5 μm. Asexual morph:
Ascospores filiform, multi-septate, breaking into 64 part-spores, cylindrical to fusoid, 10–12 × 1.5–2.5 μm. Asexual morph:  Synnemata arising from head, thorax, abdomen regions of host, solitary, multiple, cylindrical, unbranched, brown to dark brown at the base, light brown to grey towards the apex, 4–20 × 0.5–1 mm, fertile part located at the two-thirds length of the synnemata.
Synnemata arising from head, thorax, abdomen regions of host, solitary, multiple, cylindrical, unbranched, brown to dark brown at the base, light brown to grey towards the apex, 4–20 × 0.5–1 mm, fertile part located at the two-thirds length of the synnemata.  Conidiogenous cells hymenostilbe-like, phialidic, forming a hymenial layer. Phialides cylindrical with short crowded denticles, 10–20 × 3–4 μm.
Conidiogenous cells hymenostilbe-like, phialidic, forming a hymenial layer. Phialides cylindrical with short crowded denticles, 10–20 × 3–4 μm.  Conidia hyaline smooth-walled, fusiform, 5–10 × 2–2.5 μm.
Conidia hyaline smooth-walled, fusiform, 5–10 × 2–2.5 μm.
Culture characteristics:
Colonies on PDA attaining a diam of 10 mm in 30 d, high mycelium density, white, reverse pale yellow. Conidia and reproductive structures not observed.
PDA attaining a diam of 10 mm in 30 d, high mycelium density, white, reverse pale yellow. Conidia and reproductive structures not observed.
Reference:
Crous PW, Costa MM, Kandemir H, et al. (2023). Fungal Planet description sheets: 1550–1613. Persoonia51: 280–417.
DOI: https://doi:10.3767/persoonia.2023.51.08Mongkolsamrit S, Thanakitpipattana D, Noisripoom W, et al. (2025). Multi-locus molecular phylogenetic analysis reveals four new species and a new record of Ophiocordyceps (Ophiocordycipitaceae, Hypocreales) on dipteran hosts in Thailand. MycoKeys 119: 235–261.
DOI: https://doi.org/10.3897/mycokeys.119.155439Species |
Strain |
Compound |
Pubchem CID |
Biological activity |
Reference |
|---|
|
Strain |
- | PV170898 | PV170899 | PV170900 |
|---|---|---|---|---|
| BCC 22048 | - | - | - | - |
| BCC 78339 | - | - | - | - |
| BCC 79225 | - | - | - | - |
| BCC 79871 | - | - | - | - |
| BCC 79872 | - | - | - | - |